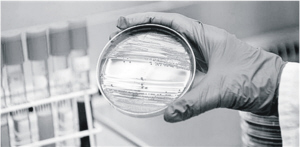

|
最近,“超级淋病”一词成为中、美等多国媒体的共同热词。然而,美国相关卫生机构早在两星期前就已辟谣:美国并没有发现“超级淋病”。
那么,谣言是怎样越传越玄乎,甚至还出来“传染性或超过艾滋病”这样惊人之语的呢?
事件的始作俑者应该是夏威夷媒体。据夏威夷州卫生部门5月1日发表的澄清声明,4月30日晚,一家当地媒体播出电视新闻称“夏威夷出现超级淋病菌”。这则新闻将当地发现的一种普通耐药性病菌与此前在日本发现的“超级淋病菌”错误地联系在一起。事实上两者不是一回事,而且夏威夷发现的患者早已治愈。
就是这样一个“小乌龙”,引得众多国际媒体以讹传讹,演变成“超级乌龙”。
美联社5月1日以檀香山电头发出一则消息:据报道,当地卫生官员证实发现两例“超级淋病”患者,他们感染的是一种被称为H041的“超级淋病菌”。
如果确有此事,那毫无疑问是重大新闻。2011年在第19届国际性病大会上,一个国际传染病研究团队专题报告了有关耐药菌株H041的发现:这一菌株2009年首次在日本一名31岁的性工作者身上检测到,它对几乎所有抗生素都有耐药性。该团队还强调,此菌株有可能在一段时间内扩散到其他地区,应引起重视。
实际上“夏威夷发现超级淋病菌”只是虚惊一场。夏威夷州卫生部门的声明发出后,美联社撤销了稿件,但全球多家媒体已把此消息传得满天飞。
美国CNBC电视台的报道最耸人听闻,它采访的一名所谓专家发出惊人之语:“从短期来看,这一菌株一旦传染起来,其后果可能比艾滋病还要糟糕得多。它的传染性更强,能在短时间内传染更多的人……被传染者可能在短短几天内出现脓毒性休克症状甚至死亡”。英国《太阳报》则称其为“全球杀手”,尽管其报道也提到这一菌株迄今没有造成一人死亡。
此后,很多专家在接受媒体采访时都指出CNBC报道的问题:淋球菌耐药性确实是比较严重的问题,但没有理由把一种病菌和一种病毒放在一起比较,“艾滋病传染致命,而死于淋球菌的人相当罕见”。
CNBC还声称,美国加州以及挪威也曾发现过H041,美国卫生部门为此还出面辟谣。事实上,H041自2009年在日本惊鸿一瞥后,就未再现身影。
不实报道点燃了许多媒体的兴奋点,“超级淋病传染性或超过艾滋病”这一说法被大量转引。中国也有人翻译了相关新闻,引起媒体和网友关注。随后,中国疾病预防控制中心性病艾滋病预防控制中心也进行了澄清。
光明网2013.5.16


 下一版
下一版




